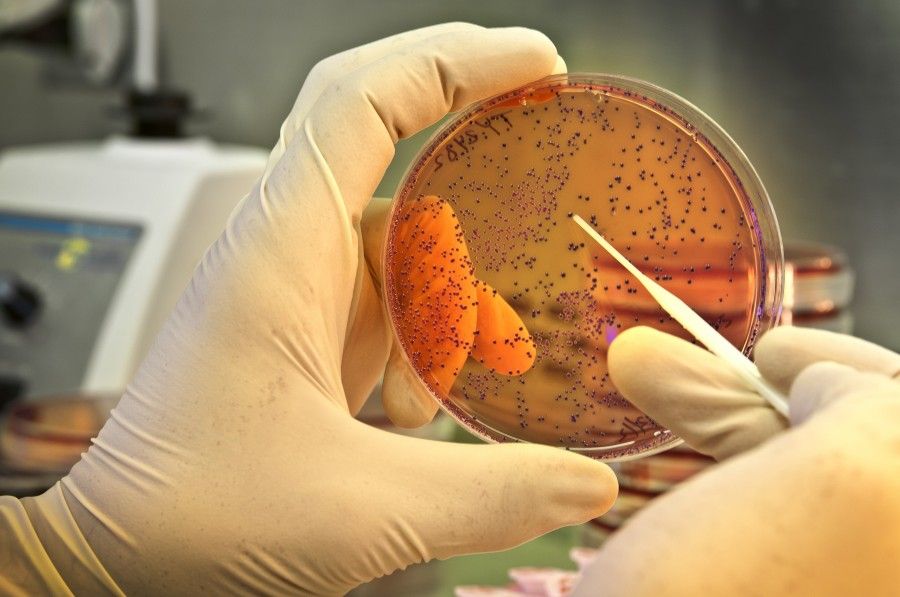
Alerta por un brote de Salmonella en Berazategui con 2 muertos por comer carne y derivados

Alerta por un brote de Salmonella en Berazategui con 2 muertos por comer carne y derivados
Melina Alderete
En las primeras semanas de enero, un brote de supuesto origen alimentario alertó a los vecinos y vecinas de Berazategui y alrededores, tras la aparición de cuatro casos de adultos internados por diarrea aguda, tres de ellos en el Hospital Evita Pueblo y uno en una clínica privada.
Según la comunicación epidemiológica del Municipio de Berazategui y del Ministerio de Salud de la Provincia de Buenos Aires, los casos presentaban antecedentes de ingesta reciente de carne y derivados, por lo que ambas autoridades buscan generar conciencia sobre la vigilancia de casos y enfatizar el manejo seguro de alimentos para la población.
Actualmente, los organismos pertinentes se encuentran a la espera de los resultados de diagnóstico etiológico que permitan definir el o los agentes involucrados. Mientras tanto, insisten en el abordaje y notificación de la llegada de pacientes de cualquier edad con antecedente de diarrea, vómitos o sintomatología compatible con intoxicación alimentaria que requiera internación correspondiente al municipio de Berazategui o municipios colindantes.
Los casos
En base al documento presentado por el del Municipio de Berazategui y del Ministerio de Salud de la Provincia de Buenos Aires, actualmente se han identificado como pacientes afectados por la circulación del brote, un hombre de 48 años que fue diagnosticado con la presencia de Salmonella typhimurium y falleció el día 12 de enero.
Días anteriores a su llegada al centro médico, el paciente fallecido refirió haber consumido achuras y carne “con sabor desagradable”. Posteriormente, se realizó clausura y decomiso de alimentos en la carnicería identificada.

Otro de los pacientes confirmados fue un hombre de 36 años de edad, que inició con tos, cefalea y fiebre el 13 de enero, a lo que se agregó diarrea al día siguiente. El 16 de enero, el mismo fue internado con un cuadro de diarrea, vómitos, fiebre, shock séptico y fallo multiorgánico. Según la comunicación epidemiológica ya mencionada, el hombre había consumido albóndigas recalentadas el día 12 de enero. Finalmente, el 17 de enero el paciente falleció y se procedió a la inspección y decomiso de alimentos en la carnicería identificada.
Además de los fallecidos, a la lista de casos se le suman dos pacientes más que se encuentran en estado de internación: Un hombre de 40 años, cuyo resultado de muestras biológicas arrojó la presencia de Salmonella sp y, según el comunicado, había consumido carne del mismo establecimiento que el hombre de 48 años.
El otro paciente es un hombre de 47 años que permanece en la Unidad de Cuidados Intensivos y evoluciona desfavorablemente, con presencia de falla multiorgánica. Según lo referido por el paciente, el 16 de enero había consumido embutidos y churrascos, comprados en una carnicería del municipio.
A partir de la notificación de estos casos, desde la Dirección de Vigilancia Epidemiológica y Control de Brotes de la Provincia se realiza una búsqueda retrospectiva de casos de diarrea aguda o con clínica compatible con intoxicación alimentaria, con domicilio en Berazategui y municipios aledaños, notificados en el SNVS-SISA y en establecimientos de cabecera.
Asimismo, según el documento oficial, desde el 1 de enero de 2023 a la fecha no se registraron otros casos compatibles ni incremento inusual de casos de diarrea aguda. Sin embargo, se insiste en que los casos vinculados a una sospecha de brote constituyen eventos de notificación obligatoria al Sistema Nacional de Vigilancia de la Salud (SNVS) en el marco de la ley 15.465 y la resolución 2827/2022.
Qué hacer para prevenir un brote
A la población, desde el Municipio de Berazategui y el Ministerio de Salud, se le recomienda utilizar agua segura, practicar costumbres de higiene, como el lavado de manos habitual; utilizar alimentos frescos, limpios, bien cocinados y recientemente preparados; lavar y cocinar de forma adecuada los vegetales y demás alimentos y evitar la contaminación cruzada.
Además, se hace hincapié en que, para ser ingeridas, las carnes deben estar bien cocidas por dentro y por fuera, hasta que pierdan totalmente el color rosado, teniendo especial cuidado con la carne picada, hamburguesas, albóndigas, empanadas, pastel de carne, achuras, etc. La cocción correcta implica cocinar completamente la pieza, hasta que no queden partes rosadas en su interior y sus jugos sean claros.
Si la carne tiene mal olor al momento de prepararla, o perdió la cadena de frío, se recomienda no consumirla. Asimismo, las carnes no deben descongelarse más de una vez en caso de haber sido frizadas. También se enfatiza en la no utilización del mismo cuchillo, tabla o mesada donde se apoyó carne cruda para cortar otros alimentos, sin antes lavarlos con agua y detergente.




